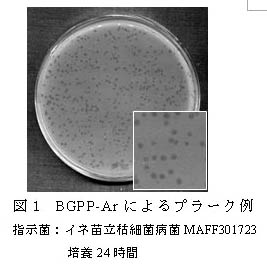

イネのもみ枯細菌病と苗立枯細菌病の両方を防除できるファージ | ||||||
| [要約] | ||||||
イネもみ枯細菌病菌とイネ苗立枯細菌病菌の両菌に感染するファージをイネ種子の催芽時に処理することにより、育苗期に発生する2つの病害を防除することができる。 | ||||||
[キーワード]イネ、ファージ、イネもみ枯細菌病、イネ苗立枯細菌病 |
||||||
[担当]石川農研・資源加工研究部・生物資源グループ [代表連絡先]電話:076-257-6911 [区分]関東東海北陸農業・北陸・生産環境 [分類]研究・参考 |
||||||
| [背景・ねらい] | ||||||
これまでに、イネ苗立枯細菌病菌に感染するファージBPP-Yaを発見し、これを種子浸漬に用いることで、苗立枯細菌病の発病を抑制できることを明らかにしている。イネの育苗期には、苗立枯細菌病に加えてもみ枯細菌病の発生も多いことから、これら両病害を防除することができるファージを探索し、その防除効果を明らかにする。 | ||||||
[成果の内容・特徴] | ||||||
| ||||||
[成果の活用面・留意点] | ||||||
| ||||||
[具体的データ] | ||||||
| ||||||
[その他] | ||||||
研究課題名:IPM(総合的病害虫管理)による水稲の減農薬防除技術の開発 | ||||||
|
| ||||||
| 目次へ戻る |